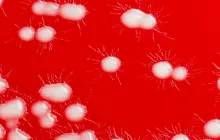
How to Reduce Risk of Bacterial Infections

Understanding the Connection Between Stress and Immunity
Stress is not merely a fleeting mood or a momentary feeling of pressure. It is a complex physiological cascade that involves the brain, the endocrine system, and the immune system working in concert to prepare the body to respond to challenges. The immune system does not operate in isolation; it relies on signals from the brain to determine how aggressively to defend the body and when to conserve energy for healing. This bidirectional dialogue, studied within the field of psychoneuroimmunology, helps explain why emotional states such as anxiety, fear, or chronic worry can translate into measurable changes in immune function. When stress is brief and manageable, these responses can be adaptive, mobilizing energy and resources to deal with immediate threats. Yet when stress becomes chronic or excessive, the same regulatory networks can shift toward a state that hinders immune efficiency, delays healing, and increases susceptibility to infection. The transition from a short-term adaptive response to a long-term impairment is not automatic or universal, but it is well supported by a growing body of research that links sustained activation of stress pathways with changes in how the body detects, communicates with, and deploys immune defenses. The result is a nuanced picture in which the immune system is both a recipient and a mediator of stress signals, with outcomes that shape health in ways that are visible in everyday life, from a longer cold to slower recovery from minor injuries.
To understand how stress sculpted immune outcomes, it is helpful to consider the central players involved. The hypothalamus, a small region at the base of the brain, interprets stress and triggers the release of hormones that travel through the bloodstream to reach distant targets. Among these messengers, cortisol stands out as a principal regulator. Cortisol helps mobilize energy by adjusting metabolism, suppressing nonessential inflammatory responses, and orchestrating a wide array of physiological adjustments that keep you alert and prepared. At the same time, the sympathetic nervous system releases catecholamines like adrenaline, which prime tissues for rapid action. Together, these systems create a cascade that can temporarily recalibrate immune activity—sharpening certain defenses while dampening others. Over time, persistent exposure to these signals can alter the behavior of immune cells, influence the balance between pro-inflammatory and anti-inflammatory mediators, and modify how immune tissues respond to real pathogens. The outcome is not a single symptom or disease but a shift in the immune landscape that can manifest as increased vulnerability to infections, slower healing, and a tendency toward chronic, low-grade inflammation that underpins many chronic conditions.
What Happens in Your Body When Stress Persists
When stress persists, the body transitions from a fast, tactical response to a longer-term mode of regulation that has profound implications for immunity. Chronic activation of the HPA axis, which governs the release of cortisol and related hormones, can blunt the production and function of critical immune cells. Natural killer cells, essential for early defense against viruses and tumor cells, may become less efficient, while certain T cells and B cells may shift their behavior in ways that reduce the breadth and speed of antibody production. In parallel, chronic stress often sustains a state of low-grade inflammation, characterized by the ongoing release of inflammatory cytokines such as interleukin-6 and tumor necrosis factor-alpha. Although these molecules are essential for fighting infections, their prolonged presence can disrupt immune regulation, contribute to tissue damage, and paradoxically impair the body's ability to mount a precise and effective response to new challenges. The hormonal milieu of chronic stress can also alter mucosal barriers, including those in the gut and respiratory tract, potentially increasing permeability and allowing greater exposure to foreign substances that trigger immune reactions. The net effect is a body that remains alert and ready to defend against threats while its resources for actual defense against new pathogens are diverted or dulled.
Beyond these cellular shifts, chronic stress can influence sleep, nutrition, and physical activity patterns, each of which feeds back into immune function. Sleep is a critical regulator of immune health because it supports the production of protective cytokines and the activity of immune cells during restorative cycles. When stress disrupts sleep, the nighttime choreography of immune surveillance can falter, leaving the body more vulnerable. Similarly, stress can steer dietary choices toward energy-dense but nutrient-poor foods, reducing intake of vitamins, minerals, and antioxidants that support immune resilience. Exercise, another major regulator of immunity, demonstrates a similar bidirectional relationship with stress. Moderate, consistent physical activity tends to strengthen immune defenses and reduce perceived stress, whereas excessive training or irregular activity patterns can temporarily suppress certain immune functions. The interplay of these factors means that the immune system does not respond to stress in a vacuum; it is shaped by daily habits, sleep quality, and overall lifestyle, all of which can amplify or dampen the impact of stress on health.
Acute Stress vs Chronic Stress: Different Impacts
Not all stress is created equal, and the immune consequences of stress depend on its duration and intensity. Acute stress, when experienced briefly and managed effectively, can produce a transient boost in certain immune activities. This phenomenon, sometimes called immune “priming,” may help you respond to an immediate challenge by enhancing barrier defenses and promoting rapid mobilization of immune cells. The body treats a sudden threat as a call to arms, and for a short period, immune surveillance can be heightened. Yet this burst is designed to be temporary. If the stressor subsides, immune function often returns to baseline. Problems arise when stress becomes chronic, or when people experience repeated acute stressors that do not allow the system to recover fully. In these cases, the initial beneficial aspects of immune activation can transform into maladaptive patterns. Prolonged exposure to stress hormones reduces the efficiency of immune cell interactions, impairs the generation of high-quality antibodies, and sustains inflammatory signaling that keeps tissues in a heightened state of reactivity. The cumulative effect is that an individual may experience more frequent or longer-lasting infections, slower wound healing, and a higher likelihood of inflammatory conditions that can complicate recovery from illnesses. In clinical terms, the distinction between acute and chronic stress is a crucial driver of how stress translates into health outcomes, and it helps explain why people with similar daily pressures might show very different immune trajectories.
In addition to direct hormonal effects, chronic stress can alter the way immune organs, such as the thymus, spleen, and lymph nodes, develop and function over time. These changes can influence the repertoire of immune cells available to recognize pathogens, as well as the signaling networks that guide their activation and suppression. The brain’s perception of stress also matters. Two individuals facing the same external stressor may experience very different physiological responses based on past experiences, coping resources, and social support. Psychological resilience, social connectedness, and a sense of control can buffer some of the immune disturbances associated with stress, illustrating how mental and emotional health intertwine with physical health at the most fundamental levels.
Immunological Pathways Affected by Stress
The immune system is a network of innate and adaptive components, and stress can perturb both sides of that network in multiple ways. Innate immunity, which provides the first line of defense, relies on cells that can rapidly recognize common features of pathogens. Under sustained stress, the activity of these cells can become inconsistent; some signals may be amplified while others are dampened. Adaptive immunity, which provides pathogen-specific responses and immunological memory, can also be altered. T lymphocytes, including helper and cytotoxic subsets, require a careful balance of signals to coordinate responses that are strong enough to clear invaders but restrained enough to avoid collateral damage. Chronic stress can tilt this balance, reducing the efficiency of T cell responses and shifting the cytokine environment toward a pro-inflammatory profile that persists beyond the initial threat. B cells, responsible for producing antibodies, may display changes in activation and maturation that influence the quality and specificity of humoral responses. These cellular shifts can translate into slower clearance of infections, reduced vaccine responsiveness, or diminished capacity to neutralize emerging pathogens. The mucosal surfaces, including the lining of the gut and airways, are particularly sensitive to stress, as local immune defenses at these interfaces depend on a finely tuned crosstalk between epithelial barriers, resident immune cells, and the microbiome. When stress disrupts this crosstalk, mucosal immunity can weaken, creating a vulnerability to respiratory and gastrointestinal infections.
Beyond cellular actors, stress also shapes the inflammatory milieu. Inflammation is a natural and necessary component of defense, but unchecked or chronic inflammatory signaling can impair tissue repair, hinder coordinated immune responses, and contribute to a cycle of tissue damage that perpetuates further immune activation. Hormones such as cortisol, adrenaline, and noradrenaline exert rhythmically timed effects on the production of cytokines, chemokines, and growth factors that guide the movement and function of immune cells. The net result is a dynamic, context-dependent pattern where the same stress response that helps you react quickly to danger can, over time, disorganize the precise choreography required for effective immunity. The body is not simply pushed into a weaker state by stress; rather, the immune system becomes less predictable, less adaptable, and less able to coordinate an efficient defense when new threats arise.
The Role of Sleep and Stress
Sleep and stress share a reciprocal relationship that has a powerful impact on immune health. When stress disrupts sleep, the restorative processes that underpin effective immune function are compromised. Deep, slow-wave sleep and rapid eye movement (REM) sleep contribute to the regulation of cytokines and the maturation of immune cells. Lack of sufficient sleep can lower natural killer cell activity, reduce the production of antiviral antibodies, and alter the balance of pro- and anti-inflammatory signals. Conversely, poor immune performance can increase fatigue and irritability, which can magnify perceived stress and further disrupt sleep, creating a bidirectional loop that undermines resilience over time. The timing and quality of sleep matter as much as the total duration. Irregular sleep schedules, fragmentation, and circadian misalignment interfere with the synchronized release of immune mediators and impair coordinated responses to infections. Protecting sleep integrity, therefore, is not a luxury but a foundational strategy for preserving immune competence in the face of daily stressors.
In addition to sleep quantity, sleep quality influences melatonin production, a hormone with immunomodulatory properties that helps regulate inflammatory processes and supports antioxidant defenses. When stress suppresses melatonin by increasing light exposure at night, erratic wake times, or excessive caffeine consumption, the body’s defense against oxidative damage can waver. Melatonin also interacts with the immune system by dampening excessive inflammatory responses while enabling efficient activation when a real threat is detected. In practical terms this means that people who consistently deprive themselves of restful sleep are more likely to experience prolonged illnesses, slower recovery from injuries, and a higher chance of mild infections developing into more persistent conditions. The interplay among stress, sleep, and immunity highlights how lifestyle choices ripple through health in a cascade that begins with the brain’s interpretation of stress and ends with the body’s capacity to fend off disease.
Nutrition, Exercise, and Stress Resilience
Nutrition plays a central role in supporting the immune system, and stress can influence eating patterns in ways that either bolster or undermine immune resilience. A diet rich in fruits, vegetables, whole grains, lean proteins, healthy fats, and micronutrients such as zinc, selenium, vitamin C, and vitamin D provides building blocks for immune cells and helps regulate inflammation. When stress drives reliance on highly processed, sugary, or nutrient-poor foods, immune efficiency can suffer. Chronic intake of refined sugars, for instance, can transiently impair neutrophil function and reduce the effectiveness of antibody responses, while inadequate intake of key micronutrients can dampen the activities of cells responsible for detecting pathogens. Exercise is another powerful modifier of immune function and stress. Regular, moderate physical activity tends to enhance immune surveillance, improve sleep, and reduce perceived stress, supporting a more robust defense system. On the other hand, excessive or highly intense training without adequate recovery can temporarily suppress immune activity, particularly after long endurance events or heavy training blocks. The overall message is that balanced nutrition and steady, purposeful activity contribute to a resilient immune system that can better withstand the wear and tear caused by stress.
In addition to diet and exercise, other lifestyle factors shape how stress affects immunity. Adequate hydration, exposure to daylight, and the management of caffeine and alcohol intake all influence physiological arousal, sleep quality, and inflammatory signaling. Chronic stress often leads to the adoption of habits that undermine health, whereas deliberate choices aimed at reducing stress exposure and promoting restorative routines can strengthen immune defenses. Mindful approaches such as paced breathing, progressive muscle relaxation, and short periods of quiet reflection can lower sympathetic arousal and create a more favorable hormonal environment for immune cells to operate effectively. Together, nutrition, movement, and mindful living form a triad that empowers the immune system to meet threats with greater efficiency, even when stress levels remain elevated.
Mental Health, Coping, and Immunity
The emotional and cognitive landscape in which a person lives has a measurable impact on immune function. Chronic anxiety, rumination, or depressive symptoms are associated with detectable shifts in immune signaling, including higher baseline inflammation and altered antibody dynamics. When the mind is persistently flooded with stress-related thoughts, the immune system may respond in ways that favor vigilance over repair, a state that can hinder healing and reduce resilience to new infections. Conversely, healthy coping strategies can buffer these effects. Practices that cultivate emotional regulation, social connectedness, and a sense of control have been linked with healthier immune profiles. Social support, whether from friends, family, or communities, contributes to reductions in perceived stress and improvements in sleep quality, both of which have downstream benefits for immune competence. Mindfulness-based interventions, cognitive-behavioral approaches, and other evidence-based therapies can help reframe stressors, reduce chronic arousal, and restore a more balanced immune response over time. The takeaway is that improving mental health is not separate from physical health; it is inextricably connected to how well the body can defend itself against disease.
Another dimension concerns perception and interpretation. How a person appraises a stressor—the degree of control they believe they have, the predictability of the situation, and the extent to which they feel supported—can influence the intensity of the hormonal response. Even when external circumstances are unchanged, adopting coping frameworks that emphasize practical problem solving, acceptance, and adaptive pacing can reduce the cumulative burden on the immune system. In this sense, the mind’s approach to stress becomes a practical tool for maintaining health. When people integrate regular relaxation practices into their daily routine, they create physiological buffers that temper inflammatory signaling and preserve the delicate balance needed for effective immune function.
The Gut-Brain-Immune Axis
Beyond the bloodstream and bone marrow, an expansive ecosystem exists within the gut where trillions of microbes, immune cells, and nerve endings interact in a dynamic dialogue. The gut-brain-immune axis describes how stress can alter the microbiome composition, intestinal barrier integrity, and systemic immune responses. Stress-induced changes in gut motility and permeability can permit microbial components to enter the bloodstream, triggering inflammatory signals that ripple outward. A diverse and balanced microbiota supports a robust mucosal barrier, educates immune cells, and produces metabolites that influence systemic immunity and mood. Conversely, chronic stress can reduce microbial diversity, increase permeability, and promote a pro-inflammatory milieu. Diet again plays a central role, as fiber-rich foods, fermented products, and a range of polyphenols can nurture a healthy microbiome that supports both mental and immune health. Taking care of gut health is thus not merely about digestion; it is about preserving a resilient interface where the immune system constantly negotiates with the external environment.
The interplay among stress, the gut, and immunity underscores the importance of holistic habits. When stress is managed through sleep, nutrition, and mindful practices, the gut environment tends to stabilize, which in turn stabilizes immune signaling. This stabilizing effect can reduce the frequency and severity of infections, support faster healing, and improve overall well-being. Such integrative strategies illustrate how deeply interconnected bodily systems are and why addressing stress requires a broad, coordinated approach that includes attention to dietary patterns, gut health, social support, and cognitive well-being.
Common Illnesses and How Stress Alters Susceptibility
People under prolonged stress often report more frequent illnesses, longer durations of colds, flu, and urinary tract infections, and slower recovery from wounds. The mechanisms behind these observations are multifaceted. Impaired immune surveillance can hinder the rapid clearance of viruses, while dampened antibody production can reduce the effectiveness of vaccines and the creation of memory cells that provide future protection. Stress-related sleep disruption and poor nutrition further compromise frontline defenses, increasing vulnerability during peak infectious seasons or after injuries. Additionally, slow wound healing is a clinically relevant indicator of immune dysregulation, reflecting a cascade of cellular events in which inflammation and tissue repair processes are poorly coordinated. While genetics, age, and preexisting health conditions shape individual risk, the presence of chronic stress consistently correlates with decreased resilience. The message is practical: managing stress is not a luxury but a practical component of maintaining immune health, especially for people who interact with vulnerable populations, work in high-pressure environments, or navigate ongoing life challenges.
It is also important to acknowledge that stress does not cause disease in a binary sense. Rather, it shifts probabilities, making it more likely that infections will take hold, or that recovery will be slower, particularly when multiple risk factors converge. This probabilistic view helps explain why some individuals appear to weather stress with minimal health disruption while others experience more pronounced immune-related consequences. It also points to the value of early interventions, such as improving sleep, adopting steady exercise, and cultivating social support, as ways to tilt outcomes toward better immune performance.
How to Rebuild Immune Resilience in a Stressful World
Rebuilding immune resilience in the face of chronic life stress requires a practical, sustainable approach that encompasses daily routines, coping strategies, and environmental modifications. A central component is prioritizing sleep and creating a predictable nighttime schedule that honors the body’s circadian rhythms. Consistent sleep supports the timing of immune cell production and the regulation of inflammatory mediators, which in turn enhances the body’s ability to fend off infections and recover more quickly when illness occurs. Simultaneously, stress reduction techniques such as mindful breathing, meditation, yoga, or gentle stretching can lower baseline arousal, improve mood, and reduce the inflammatory tone associated with chronic stress. Implementing coping strategies that emphasize problem solving, realistic goal setting, and the cultivation of social connections also supports immune health by reducing the intensity and duration of stress responses. Immunity benefits when people feel supported, capable, and connected to others who share positive health behaviors.
Nutritional strategies are another essential pillar. Emphasizing whole foods rich in vitamins, minerals, and phytonutrients helps supply the materials immune cells need to function effectively. It is wise to limit highly processed foods and added sugars that can aggravate inflammation and produce swings in energy and mood. Hydration and consistent meal timing help stabilize blood sugar and hormonal oscillations, which in turn support steady immune signaling. Regular physical activity, tailored to an individual’s fitness level and health status, reinforces immune surveillance while providing a buffer against the wear of stress. Even moderate activities such as brisk walking, swimming, or cycling several times a week can produce meaningful improvements in immune resilience when paired with adequate rest. Finally, addressing environmental contributors to stress, such as a noisy or chaotic living space, work demands, or excessive screen time, creates a healthier backdrop for all the body's systems to operate in harmony.
Implementing a Personal Plan for Immune Health
A practical way to translate this knowledge into daily life is to design a personal, flexible plan that accounts for individual needs, responsibilities, and preferences. Begin by assessing sleep patterns, daily stress levels, and physical activity, then set attainable adjustments rather than sweeping changes. Small, consistent steps over weeks and months yield lasting benefits more reliably than dramatic, short-lived efforts. Build a routine that prioritizes regular sleep, balanced meals, and safe opportunities for movement, while leaving room for rest and recovery when life demands peak. Integrate stress-reduction practices that resonate personally, whether that means a 10-minute breathing session before bed, a short walk after meals, or a brief period of journaling to process concerns. Seek social support by arranging check-ins with a friend, family member, or support group who can provide encouragement and accountability. In situations where chronic stress stems from work, caregiving responsibilities, or health challenges, consider professional guidance from a counselor or clinician who can offer strategies tailored to your circumstances. The plan should be adaptable, measurable, and compassionate toward yourself as you implement changes.
Tracking progress is not merely about tallying numbers but about recognizing patterns, recognizing what improves mood, sleep, and energy, and understanding how these gains translate into better immune readiness. A practical approach includes reflecting on sleep quality, mood, appetite, and energy levels, and noting any changes in infection frequency or healing speed. When signs of persistent immune compromise appear—such as unusually frequent illnesses, unusually slow wound healing, or persistent fatigue—reach out to a healthcare professional for a comprehensive evaluation. The aim of a personal plan is to create a sustainable environment in which the body’s defense systems can operate with clarity and efficiency, even during challenging times.
A Final Thought on Everyday Life and Immunity
Living with stress is part of the human experience, yet it does not have to dictate health outcomes. By understanding the ways stress can influence immune function, you can take informed steps to shield the body’s defenses. The core idea is balance: balancing sleep with wakefulness, balancing activity with rest, balancing nutrition with enjoyment of life, and balancing social connection with healthy boundaries. Small daily decisions compound over weeks and months, producing meaningful gains in resilience. When stress is managed thoughtfully, the immune system does not simply veer toward deficiency; it remains capable of recognizing threats, mounting targeted responses, and repairing tissue efficiently. This broader perspective invites patience and persistence, turning stress management from a mere survival tactic into an investment in long-term health.